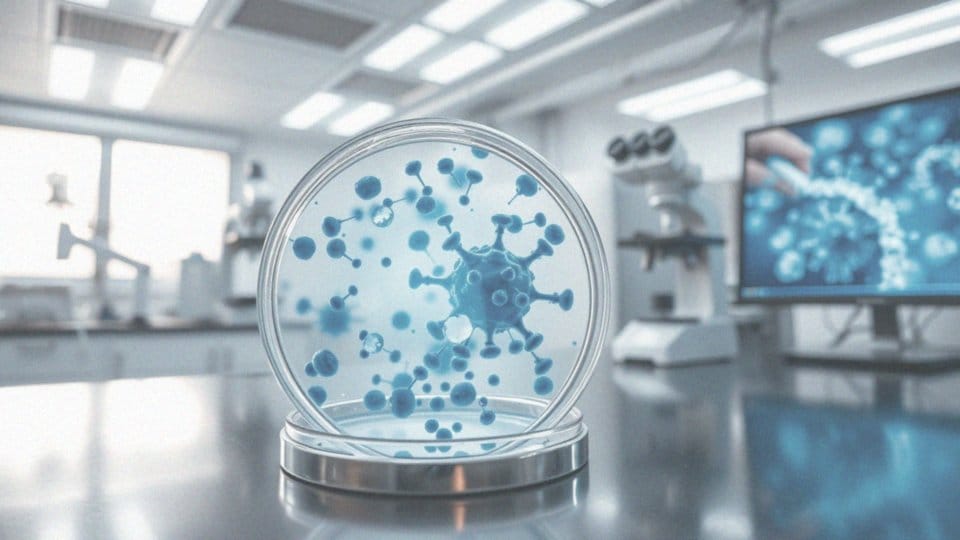

Spis treści
Co to jest Hascovir Control?
Hascovir Control to dostępny bez recepty lek przeciwwirusowy, którego kluczowym składnikiem jest acyklowir. Znajduje on zastosowanie przede wszystkim w zwalczaniu infekcji, których sprawcą jest wirus opryszczki pospolitej. Można go użyć, by pozbyć się dokuczliwej opryszczki wargowej oraz jest on efektywny w terapii opryszczki narządów płciowych u osób dorosłych. Krótko mówiąc, Hascovir Control to preparat dedykowany walce z opryszczką.
Jakie są postaci Hascovir Control?
Hascovir Control to preparat dostępny w kilku postaciach, dając pacjentom wybór najdogodniejszej metody leczenia. Można go znaleźć w formie:
- tabletek 200 mg, które połyka się popijając wodą,
- zawiesiny, przeznaczonej do picia,
- żelu do aplikacji bezpośrednio na zmienione chorobowo miejsce.
Niezależnie od formy, każdy z tych produktów Hascovir Control zawiera identyczną substancję czynną, zapewniając ten sam efekt terapeutyczny.
Jak działa Hascovir Control?
Hascovir Control to preparat, którego aktywnym składnikiem jest acyklowir. Substancja ta hamuje replikację wirusów opryszczki pospolitej (Herpes simplex) typu 1 i 2, działając w sposób wysoce specyficzny. Acyklowir, ingerując w proces powielania wirusów, efektywnie spowalnia postęp infekcji. Choć lek nie eliminuje wirusa opryszczki z organizmu na stałe, to istotnie skraca czas trwania choroby oraz łagodzi jej uciążliwe symptomy, co bezpośrednio przekłada się na poprawę samopoczucia pacjenta.
Jakie są działania substancji czynnej w Hascovir Control?
Acyklowir, serce Hascoviru Control, to substancja o silnym działaniu przeciwwirusowym. Wykazuje szczególną skuteczność w zwalczaniu:
- wirusów opryszczki (zarówno HSV-1, jak i HSV-2),
- wirusów odpowiedzialnych za ospę wietrzną i półpasiec (VZV).
Mechanizm jego działania opiera się na blokowaniu polimerazy DNA wirusa – enzymu niezbędnego do replikacji DNA wirusa. Innymi słowy, acyklowir, zakłócając ten proces, powstrzymuje wirusy przed namnażaniem się w zainfekowanych komórkach, skutecznie hamując ich rozprzestrzenianie.
W jaki sposób Hascovir Control pomaga w leczeniu opryszczki?
Hascovir Control to sprzymierzeniec w walce z opryszczką. Jego działanie opiera się na hamowaniu replikacji wirusa opryszczki pospolitej (HSV), co w konsekwencji łagodzi uciążliwe symptomy. Dzięki niemu infekcja przebiega krócej i nie rozwija się tak dynamicznie. Najlepsze efekty przynosi, gdy zastosujesz go w początkowej fazie, np. odczuwając pierwsze objawy w postaci świądu, pieczenia lub uczucia napięcia skóry. Acyklowir, kluczowy składnik leku, blokuje polimerazę DNA – enzym niezbędny wirusowi do namnażania. Mówiąc wprost, Hascovir Control powstrzymuje rozprzestrzenianie się opryszczki.
W jakich przypadkach stosuje się Hascovir Control?
Hascovir Control to skuteczny lek, który pomoże ci uporać się z opryszczką wargową i twarzy, wywoływaną przez wirusa opryszczki pospolitej (Herpes simplex). Preparat ten nie tylko zwalcza te uciążliwe infekcje skóry i błon śluzowych, które mogą pojawiać się w różnych miejscach na ciele, ale również, w niektórych przypadkach, stosowany jest profilaktycznie. U osób z prawidłowo funkcjonującym układem odpornościowym, Hascovir Control może zapobiegać nawrotom opryszczki, pozwalając uniknąć powracających, nieprzyjemnych dolegliwości. Dzięki temu, ten lek stanowi kompleksowe rozwiązanie w walce ze skutkami zakażenia wirusem opryszczki, oferując zarówno wsparcie w leczeniu, jak i ochronę przed ponownym pojawieniem się choroby.
Jakie jest zalecane dawkowanie Hascovir Control?

Zalecana dawka leku Hascovir Control dla osób dorosłych to jedna tabletka o zawartości 200 mg. Należy ją zażywać pięć razy w ciągu dnia, zachowując regularny odstęp czterech godzin między kolejnymi dawkami, z uwzględnieniem przerwy nocnej na sen. Tabletkę połknij w całości, popijając ją szklanką wody. Aby terapia była jak najbardziej skuteczna, rozpocznij ją niezwłocznie po wystąpieniu pierwszych symptomów opryszczki. Pamiętaj również o dostarczaniu organizmowi odpowiedniej ilości płynów w trakcie kuracji Hascovirem Control – to niezwykle istotne dla Twojego zdrowia i samopoczucia.
Jak długo powinno trwać leczenie Hascovir Control?
Standardowo terapia Hascovirem Control trwa 5 dni i kluczowe jest, by rygorystycznie się tej zasady trzymać. Nawet jeśli poprawa nastąpi szybciej, nie należy przedwcześnie rezygnować z leczenia, ponieważ może to skutkować nawrotem infekcji. A co zrobić, gdy, mimo stosowania leku, symptomy zamiast ustępować, stają się bardziej dokuczliwe? W takim przypadku niezwłocznie skonsultuj się z lekarzem, który najlepiej oceni, co się dzieje. Nie bagatelizuj pogarszającego się samopoczucia i pamiętaj o konsekwentnym przyjmowaniu leku, zgodnie z instrukcjami.
Jakie są przeciwwskazania do stosowania Hascovir Control?
Przeciwwskazaniem do stosowania Hascovir Control jest nadwrażliwość na:
- acyklowir,
- walacyklowir,
- którykolwiek inny składnik preparatu.
Pacjenci z problemami z nerkami, a w szczególności osoby starsze, powinny zachować szczególną ostrożność podczas jego stosowania, bowiem u seniorów często występują zaburzenia czynności nerek. Nie zaleca się podawania tego leku dzieciom poniżej drugiego roku życia ze względu na brak wystarczających danych dotyczących bezpieczeństwa u najmłodszych. Niemniej jednak, ostateczną decyzję o zastosowaniu leku u tak małych dzieci zawsze podejmuje lekarz, który indywidualnie oceni potencjalne korzyści i możliwe ryzyko.
Jakie skutki uboczne może powodować Hascovir Control?

Tak jak każdy lek, Hascovir Control, choć nie u każdego, może powodować działania niepożądane. Do najczęstszych zalicza się:
- ból i zawroty głowy,
- problemy żołądkowo-jelitowe, takie jak nudności, wymioty, biegunka czy bóle brzucha,
- zmęczenie,
- gorączka,
- reakcje skórne, objawiające się wysypką, świądem, pokrzywką lub nadwrażliwością na promienie słoneczne.
Rzadziej zgłaszano wypadanie włosów oraz obrzęk naczynioruchowy. W naprawdę sporadycznych przypadkach zdarzają się poważne reakcje alergiczne, w tym anafilaksja i duszności. Warto wiedzieć, że Hascovir Control może wpłynąć na wyniki badań laboratoryjnych, podnosząc stężenie bilirubiny, aktywność enzymów wątrobowych, a także stężenie mocznika i kreatyniny we krwi. Niekiedy obserwowano również niedokrwistość, leukopenię (zmniejszenie liczby białych krwinek) oraz małopłytkowość (zmniejszenie liczby płytek krwi). Bardzo rzadko odnotowywano zaburzenia psychiczne, takie jak pobudzenie, dezorientacja, omamy oraz objawy psychotyczne. Dodatkowo, mogą pojawić się objawy neurologiczne, np. drżenia, niezborność ruchowa, problemy z mową, drgawki i senność. W pojedynczych, skrajnych przypadkach wystąpiła encefalopatia, a także – bardzo rzadko – zapalenie wątroby, żółtaczka, ostra niewydolność nerek, a nawet śpiączka. Pamiętaj, że w razie zaobserwowania jakichkolwiek niepokojących symptomów, konieczna jest konsultacja z lekarzem, szczególnie jeśli pojawią się ciężkie reakcje alergiczne lub objawy neurologiczne. Nie ignoruj tych sygnałów i nie odkładaj wizyty u specjalisty!
Dlaczego Hascovir Control nie jest zalecany w ciąży?
Hascovir Control nie jest zalecany dla kobiet w ciąży ze względu na zawartość acyklowiru i ograniczone dane dotyczące jego bezpieczeństwa w tym okresie. Acyklowir przenika przez łożysko, co stwarza potencjalne ryzyko dla rozwijającego się dziecka.
Stosowanie leku w ciąży wymaga szczególnej rozwagi i powinno być rozważane tylko wtedy, gdy korzyści dla matki przewyższają ryzyko dla płodu, a decyzję o jego zastosowaniu podejmuje lekarz indywidualnie oceniając sytuację pacjentki.
Jak Hascovir Control wpływa na karmienie piersią?
Hascovir Control a karmienie piersią – co musisz wiedzieć? Acyklowir, substancja czynna zawarta w leku Hascovir Control, może przedostawać się do mleka matki, dlatego zasadniczo jego stosowanie w okresie laktacji nie jest rekomendowane. Jednak w sytuacji, gdy terapia acyklowirem jest absolutnie niezbędna, kluczowa jest konsultacja z lekarzem. Dokona on rzetelnej oceny potencjalnych korzyści dla matki w odniesieniu do ewentualnego ryzyka dla niemowlęcia i może zalecić czasowe zawieszenie karmienia piersią. Podjęcie decyzji o zastosowaniu Hascoviru Control podczas laktacji wymaga dogłębnego rozważenia. Lekarz powinien prowadzić ścisłą obserwację, mając na uwadze przede wszystkim dobro i bezpieczeństwo dziecka. To ono jest tutaj priorytetem.





